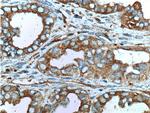
MUC16/CA125 Antibody in Immunohistochemistry (Paraffin) (IHC (P))

Search
Proteintech
MUC16/CA125 Polyclonal Antibody
{{$productOrderCtrl.translations['antibody.pdp.commerceCard.promotion.promotions']}}
{{$productOrderCtrl.translations['antibody.pdp.commerceCard.promotion.viewpromo']}}
{{$productOrderCtrl.translations['antibody.pdp.commerceCard.promotion.promocode']}}: {{promo.promoCode}} {{promo.promoTitle}} {{promo.promoDescription}}. {{$productOrderCtrl.translations['antibody.pdp.commerceCard.promotion.learnmore']}}
产品信息
20077-1-AP
种属反应
已发表种属
宿主/亚型
分类
类型
抗原
偶联物
形式
浓度
纯化类型
保存液
内含物
保存条件
运输条件
产品详细信息
The antibody recognizes the C-term of MUC16.
靶标信息
CA 125 determinant is present on a high molecular weight, mucin like glycoprotein of high molecular weight. CA 125 has been found on frozen sections of amnion and derivatives of coelomic and mullerian epithelium, including pleura, pericardium and peritoneum. In adult tissues, epithelial cells of fallopian tube, endometrium and endocervix; pancreas, colon, gall bladder, stomach, kidney, apocrine sweat gland and mammary gland. It is also found in mesothelial cell lining of pleura, pericardium and peritoneum. It is found in ovarian tumors of serous, endometrioid or clear cell types and adenocarcinomas of mullerian type.
仅用于科研。不用于诊断过程。未经明确授权不得转售。
生物信息学
蛋白别名: CA-125; ca-ovarian; CA125 ovarian cancer antigen; FLJ14303; MUC-16; Mucin-16; Ovarian cancer-related tumor marker CA125; Ovarian carcinoma antigen CA125
基因别名: CA125; MUC16
UniProt ID: (Human) Q8WXI7
Entrez Gene ID: (Human) 94025